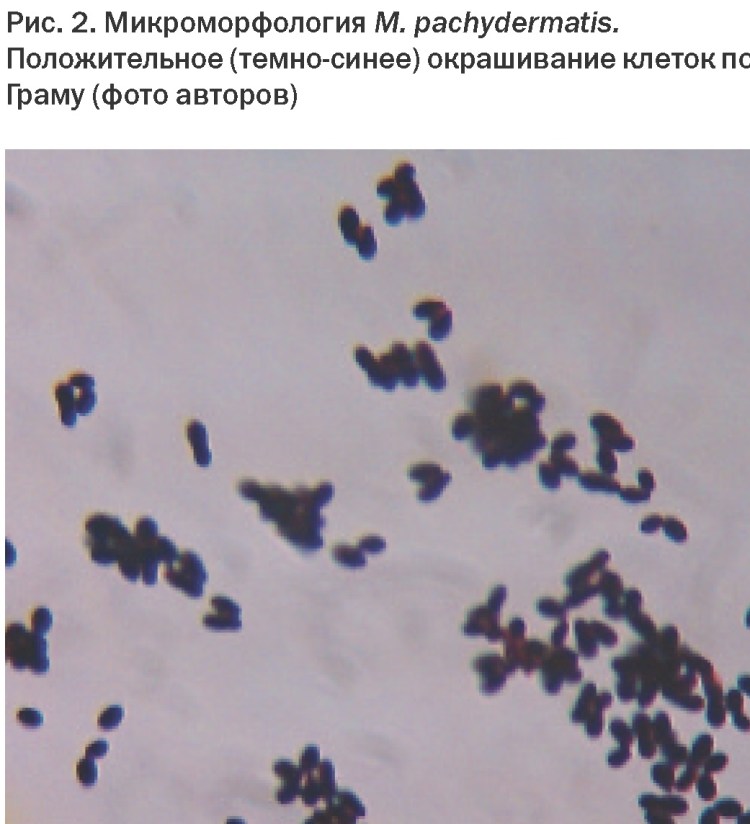
Малассезия под микроскопом
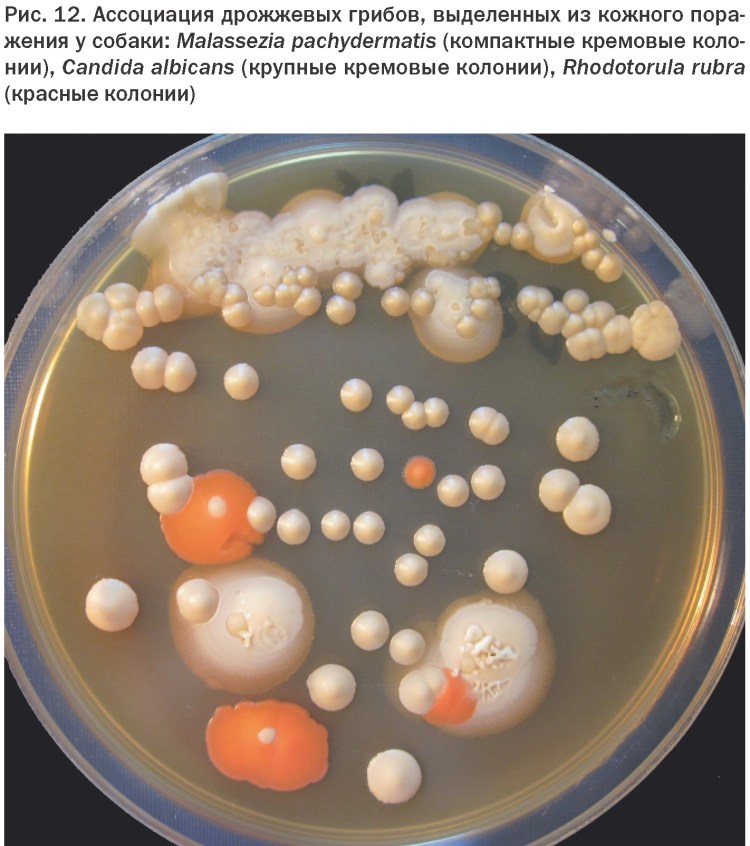
Малассезия фолликулит
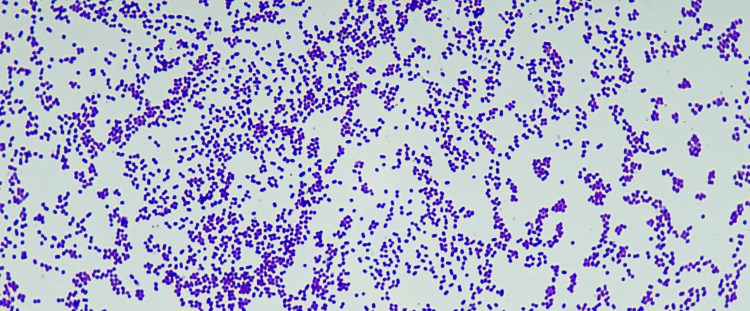
Грибы кандида микроскопия
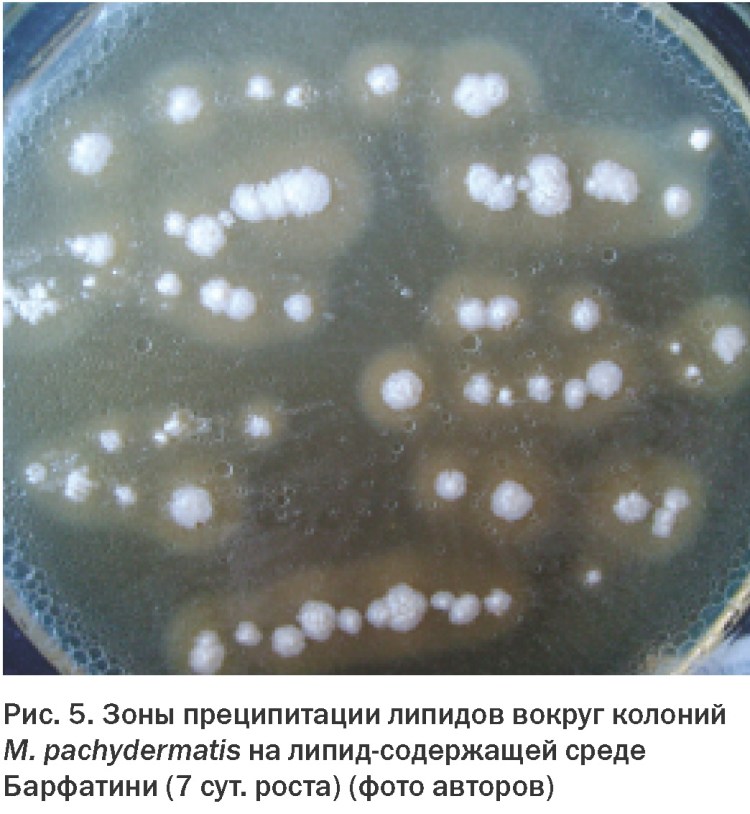
Рисунок колоний Malassezia FURFUR

![Malassezia FURFUR под микроскопом]()
Malassezia FURFUR под микроскопом
![Грибок малассезия (Malassezia)]()
Грибок малассезия (Malassezia)
![Малассезия пахидерматис]()
Малассезия пахидерматис
![Дрожжеподобные грибы рода Malassezia]()
Дрожжеподобные грибы рода Malassezia
![Малассезия микроскопия]()
Малассезия микроскопия
![Малассезия микроскопия]()
Малассезия микроскопия
![Малассезия микроскопия]()
Малассезия микроскопия
![Окраска мазков дифф-Квик.]()
Окраска мазков дифф-Квик.
![Малассезия мазок микроскопия]()
Малассезия мазок микроскопия
![Грибок малацезия у собак]()
Грибок малацезия у собак
![Малассезия у собак микроскопия]()
Малассезия у собак микроскопия
![Малассезия под микроскопом]()
Малассезия под микроскопом
![Дрожжеподобный грибок Malassezia]()
Дрожжеподобный грибок Malassezia
![Mycobacterium leprae грамположительные]()
Mycobacterium leprae грамположительные
![Дрожжеподобный грибок Malassezia]()
Дрожжеподобный грибок Malassezia
![Дрожжеподобные грибы рода Malassezia]()
Дрожжеподобные грибы рода Malassezia
![Малацезия микроскопия]()
Малацезия микроскопия
![Грибок малацезия под микроскопом]()
Грибок малацезия под микроскопом
![Разноцветный лишай. Возбудитель Malassezia FURFUR.]()
Разноцветный лишай. Возбудитель Malassezia FURFUR.
![Мезотелиома цитология]()
Мезотелиома цитология
![Малассезия под микроскопом у человека в гинекологии]()
Малассезия под микроскопом у человека в гинекологии
![Малассезия пахидерматис]()
Малассезия пахидерматис
![Грибок рода малассезия]()
Грибок рода малассезия
![Corynebacterium diphtheriae микроскопия]()
Corynebacterium diphtheriae микроскопия
![Малассезия фолликулит]()
Малассезия фолликулит
![Грибок малассезия (Malassezia)]()
Грибок малассезия (Malassezia)
![Грамположительные бациллы]()
Грамположительные бациллы
![Грибы кандида микроскопия]()
Грибы кандида микроскопия
![Золотистый стафилококк микроскопия]()
Золотистый стафилококк микроскопия
![Грибок малассезия у собак]()
Грибок малассезия у собак
![Кандида по Граму]()
Кандида по Граму
![Синема бактерия]()
Синема бактерия
![Грибы рода Malassezia под микроскопом]()
Грибы рода Malassezia под микроскопом
![Трихофития микроскопия]()
Трихофития микроскопия
![Candida albicans и лептотрикс под микроскопом]()
Candida albicans и лептотрикс под микроскопом
![Кандида альбиканс микроскопия]()
Кандида альбиканс микроскопия
![Candida albicans мазок микроскопия]()
Candida albicans мазок микроскопия
![Рисунок колоний Malassezia FURFUR]()
Рисунок колоний Malassezia FURFUR
![Babesia canis строение]()
Babesia canis строение
![Малассезия микроскопия]()
Малассезия микроскопия
![Разноцветного лишая Malassezia FURFUR]()
Разноцветного лишая Malassezia FURFUR
![Грибы рода Malassezia у человека]()
Грибы рода Malassezia у человека
![Мицелий актиномицетов микроскопия]()
Мицелий актиномицетов микроскопия
![Кристаллы гемина крови человека под микроскопом]()
Кристаллы гемина крови человека под микроскопом
![Малассезиозный отит капли]()
Малассезиозный отит капли
![Pityrosporum ovale и Pityrosporum orbiculare]()
Pityrosporum ovale и Pityrosporum orbiculare
![Стафилококк ауреус микроскоп]()
Стафилококк ауреус микроскоп
![Actinobacillus actinomycetemcomitans морфология]()
Actinobacillus actinomycetemcomitans морфология
![Бактерии, малацезия]()
Бактерии, малацезия
![Lactobacillus Acidophilus под микроскопом]()
Lactobacillus Acidophilus под микроскопом
![Malassezia FURFUR микробиология]()
Malassezia FURFUR микробиология
![Антропофильные дерматофиты]()
Антропофильные дерматофиты
![Стафилококк ауреус]()
Стафилококк ауреус
![Стафилококк ауреус микроскопия]()
Стафилококк ауреус микроскопия
![Уропатогенный хромагар]()
Уропатогенный хромагар
![]()
![]()
![]()
![]()
![]()
![]()
![]()